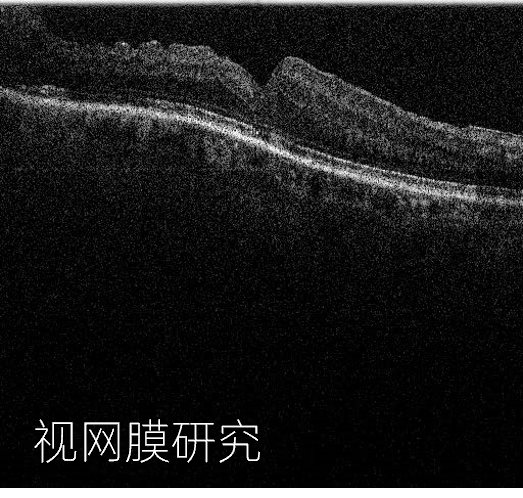
f90e2a9c-ea57-11ed-ba01-dac502259ad0.png

时间:2023-05-05 09:48
人气:
作者:admin
如果说超声可以被认为是声纳的缩小版、光学相干断层扫描(OCT)就是相当于雷达的缩小版。像雷达一样,OCT用电磁波照射其目标并测量 ”回波“产生的深度,形成一个深度分辨的图像。OCT光源通常使用红外波段,探测目标通常是生物样品或透明/半透明工件。



回波探测



但与雷达、声纳和超声波不同,OCT并不能依靠简单地通过快速测量回波强度信号或时延来形成一个三维图像。
因为对于小目标检测,比如一个典型的人体细胞的大小约为10微米,光所经过的时间为0.000033纳秒。0.000033纳秒的探测时间分辨率--对于当今最快的探测器来说也难以解决,所以与之不同的是,OCT利用干涉原理来确定光子在样本内反射的深度。性能上,超声波可以以毫米级的分辨率看到几厘米的组织;OCT可以看到几毫米深度的组织,但分辨率为μm级。在透明或半透明的样品中,OCT可以看得更深。

OCT工作原理
低相干干涉测量 OCT 的核心是干涉测量原理。想象一个输出单一频率的光源,它可以在空间和时间上表示为正弦波。如果我们将该光分成两条路径,长度可能相同也可能不同,然后重新组合这两条路径,我们将观察到干涉现象。如果这两条路径的距离完全相等,那么这两条光束将重新组合;两者的波峰和波谷将同时同步到达,输出波的强度将是任何一列波的两倍。但是,如果这两条路径恰好相差半个波长,那么一个波的波峰现在将与另一个波的波谷同步。这两个波会干涉相互抵消,导致没有输出。


相长干涉与相消干涉
完成这种波分裂和重组的装置是便是干涉仪,它对其两条路径之间的距离差异非常敏感,将宽带光分成两条路径,一条称为参考路径使用镜子以已知路径长度反射光信号;另一条路径则是要成像的样品臂。从对应于由参考镜设置的路径长度的深度反射的光的存在或不存在决定了检测到的干涉信号的存在与否。

上图本质上是一个具有一个可移动镜子的迈克尔逊干涉仪

如上所述,光学相长干涉与相消干涉说明干涉信号蕴含着光程差/位移/深度信息,OCT测量的基本原理便是这样。当然,关于频域信号时域信号转化,以及变为可视化的图像还涉及扫描同步与更复杂的傅里叶变换与信号处理算法。我们将在后续的文章中为大家带来更多干货分享,欢迎持续关注。


技术优势
在传统的谱域SD-OCT系统中,宽带光源和光谱仪是最昂贵的元件,虹科提供的lumedica-OQ LabScope系列便携式小巧紧凑的OCT成像系统采用了独创的光路设计与工艺技术路线,并通过算法克服了由非制冷SLD光源的强度波动引起的成像伪影,使用高像素CMOS线阵列设计了一个特制环形光谱仪。并采用了3D打印制造外壳,整个系统安装在一个金属板外壳中,外壳大小与鞋盒差不多,还在其中集成了微型PC计算机。

高度集成、专利设计、低成本的架构,使研究人员,创新研发人员,工厂测试人员和教育工作者都能够利用OCT强大的成像能力。

!
成本高昂的OCT技术已被重新定义

1. 经济实惠
OQ LabScope的价格是任何其他OCT系统的一个小部分。现在,许多科研/工业实验室将能够负担得起这项技术
2. 高精度
OQ LabScope可生成512x512像素的图像,与成本高于我们三倍的OCT系统性能相当,深度分辨率可达2μm
3. 小巧紧凑
OQ LabScope大约只有一个鞋盒大小-413 x 216 x 153 mm3,不会让您的实验台显得很挤,也不需要特殊的推车放置各种电源与控制模块
4. 简单易用
交钥匙系统,直接应用,让您专注科学研究与测试测量,而不是复杂前期技术设置。该软件使用很简单,您将可以快速生成图像-最高可以80kHz-A扫描速度进行实时3D渲染
5. 可定制
OQ LabScope可根据要求为特定应用配置定制模块,可选:工作站配置-显微位移台,便携包配置-手提版本,显微物镜、不同光源波长、扫描速度


应用
无论是生物医疗、食品研究还是工业测量,虹科提供的小巧紧凑的OCT成像系统都可以轻松适配。840、1310nm多种中心波长光源可选,保证最好的可穿透性。

生物医疗
OCT技术最早用于眼科,因为对视网膜有非常良好的断层成像分析能力,皮肤、组织切片、牙齿、指甲等等。除了人体医疗相关,我们还提供专门用于小动物医疗的便携扫描头版本。


工业检测
OCT具有mm级别穿透能力与μm级别轴向分辨率,可适用于多种工业制造业无损探伤,比如陶瓷、塑料、多层薄膜等等。我们的软件还支持测量标定与层析测厚。


激光加工监测:
激光加工过程的同轴监测对于加工状态的评估非常重要,OCT技术可以实现与激光头同轴光路集成,实现实时熔深监测。


食品药品
可以针对药丸、水果、饼干等进行无损检测,对近表层形状3D成像分析,也可以对果蔬含水量、瘀伤等性状进行分析与评估。


新品推荐!

